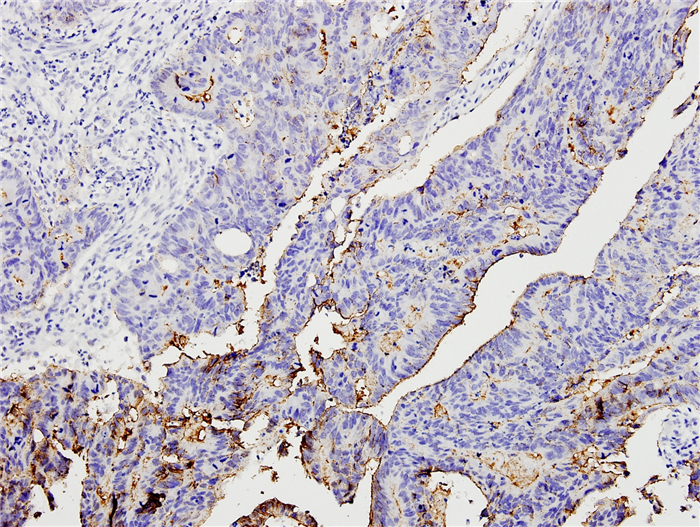

目前,结直肠癌居我国恶性肿瘤死因的第5位[1],仅次于肺癌、胃癌、肝癌、食管癌,其发病率在我国乃至世界范围内逐年上升。结直肠癌的恶性程度高,易发生血行、淋巴转移和局部侵润播散,严重危害人类健康,其发病机制一直是当前基础和临床研究的热点之一。有研究发现,上皮间质转化[2](EMT)是恶性肿瘤发生及进展的重要原因,主要表现为肿瘤边缘细胞(前缘癌细胞)紧密连接的破坏。紧密连接是相邻细胞间重要的膜连接复合体,claudin蛋白是其主要骨架蛋白[3]。多种恶性肿瘤中claudin蛋白表达异常[4],有关claudin-3在结直肠癌中表达的研究已有相关报道[5-7],关于claudin-3的表达与结肠癌发生、转移、预后的相关性目前暂无明确定论。本研究检测南方医院共62例结直肠癌组织及癌旁正常组织中claudin-3的表达,探讨claudin-3与结直肠癌发生、发展、转移及预后可能存在的关系,以期能为结直肠癌的早期诊断、治疗及预后评估提供新的有价值的理论依据。
1 资料和方法 1.1 研究对象收集2010年10月~2013年1月在南方医院接受手术治疗的结直肠癌病例40例(癌组),其中男性25例,女性15例,年龄28~82岁,平均年龄59.7岁。所有病例术前无辅助放化疗,均为一期手术切除,且保存完好的癌组织石蜡标本;同时收集22例癌旁正常组织(取自手术切除残端,距离癌组织5 cm以上,切缘阴性)作为癌旁正常组。40例癌组病例中,18例有淋巴结转移(其中4例有远处转移),22例无淋巴结转移;病理诊断结果显示,14例为高分化腺癌,19例为中分化腺癌,7例为低分化腺癌;肿瘤TNM分期分别为Ⅰ期3例,Ⅱ期19例,Ⅲ期14例,以及Ⅳ期4例;肿瘤最长径 < 5 cm者有20例,≥5 cm者有20例。所有标本均经资深病理科医师审查及筛选,且本研究经医院伦理委员会审批同意后行claudin-3免疫组化检测。
1.2 仪器和材料HM340E轮转式切片机,电热恒温水温箱,石蜡包埋机抗,显微镜(BX53 Olympus);claudin-3多克隆抗体(Abcam),SP试剂盒(北京中山金桥),DAB显色试剂盒(北京中山金桥)。
1.3 检测项目与方法 1.3.1 制作切片取每例癌组织及癌旁正常组织标本,石蜡包埋,常规做3 μm连续切片,每例连续切片4张。取1张进行病理检查,取2张分别行claudin-3免疫组织化学染色观察claudin-3蛋白表达情况,1张备用。
1.3.2 病理观察取每例癌组织及癌旁正常组织的1张石蜡组织切片,行HE染色,光镜下观察组织细胞分化程度等病理特征。
1.3.3 Claudin-3蛋白表达情况取每例癌组织及癌旁正常组织的2张石蜡组织切片,采用SP法免疫组化染色进行检测。一抗浓度1:500,按SP试剂盒说明书操作,用磷酸盐缓冲液代替一抗作为每次染色的阴性对照。结果判断标准:参考Kojima等[8]改良法的标准,随机选取至少5个400倍视野下染色细胞计数所占比例进行分级。结合染色强度和阳性细胞所占比例进行测定。染色强度评分标准:不着色为0分,黄色1分,棕黄色2分,黄褐色3分。阳性细胞所占比例评分标准:阳性细胞数 < 10%者0分,10%~ < 0%者1分,40%~ < 70%者2分,≥70%者3分。两者评分相加为claudin-3的表达得分,0~2分为阴性(-),3~4分为阳性(++),5~6分为强阳性(+++)。所有结果均进行双盲读片,阳性结果包括(+)和(++),阳性表达率为阳性(+)与强阳性(++)相加例数与该组总数的比值。
1.4 观察claudin-3蛋白表达情况与病例临床病理参数之间的关系为了进一步观察病例claudin-3蛋白表达情况与性别、年龄、肿瘤部位、肿瘤最长径、肿瘤分化程度及是否有淋巴转移等参数之间的关系,我们对癌组不同参数的病例进行了分组,比较claudin-3蛋白表达情况。
1.5 观察claudin-3蛋白表达情况与病例预后的关系对癌组40例病例进行了随访,其中7例失随访,14例术后生存期≤3年,19例术后生存期>3年。以生存期3年为限,将术后生存期≤3年的病例纳入死亡组,生存期>3年的病例纳入存活组,观察两组病例claudin-3的表达情况及其与预后的可能关系。
1.6 统计学方法所有数据采用SPSS20.0统计软件进行统计处理,癌组与癌旁正常组的claudin-3阳性表达率及强阳性表达率之间的比较采用χ2检验;癌组的临床病理学分组间的比较也采用χ2检验;术后生存期分组间的比较采用独立样本T检验;自身癌组织与癌旁正常组织的比较采用配对样本T检验。P < 0.05为差异有统计学意义。
2 结果 2.1 Claudin-3蛋白在结直肠癌组织及癌旁正常组织中的表达情况与比较免疫组化检测结果显示,claudin-3蛋白主要分布在细胞膜上,呈颗粒状或团块分布,在细胞质和细胞核亦可有表达,呈浅黄色至棕褐色不等的颗粒,基底部及腺腔内分泌物也偶尔可见一定程度的染色(图 1~3)。癌组claudin-3蛋白的阳性表达率为92.5%,高于癌旁正常组的59.09%,差异有统计学意义(χ2=10.105,P=0.003,P < 0.05);癌组claudin-3蛋白的强阳性表达率为40%,癌旁正常组为27.27%,两组差异无统计学意义(χ2=1.004,P=0.316,P>0.05,表 1)。有13例癌组织和癌旁正常组织来自同一病例,这13例病例的癌组织和癌旁正常组织中claudin-3表达平均评分分别为4.538和3.269,配对T检验分析显示,癌组织claudin-3的表达强于自身癌旁正常组织,差异有统计学意义(P=0.019,P < 0.05,图 4)。以上结果提示claudin-3蛋白在癌组织中的表达显著强于癌旁正常组织,claudin-3蛋白的异常表达可能可以作为结直肠癌的诊断指标。
|
图 1 结直肠癌高分化组织中claudin-3阴性(-)表达 Figure 1 Negative (-) claudin-3 expression in well differentiated colorectal carcinoma (SP, original magnification: ×200). |

|
图 2 结直肠癌中分化组织中claudin-3阳性(+)表达 Figure 2 Positive (+) claudin-3 expression in moderately differentiated colorectal carcinoma (SP, ×200). |

|
图 3 结直肠癌低分化组织中claudin-3强阳性(++)表达 Figure 3 strongly positive (++) expression in poorly differentiated colorectal carcinoma (SP, ×200). |
| 表 1 Claudin-3在结直肠癌组织与癌旁正常组织中的表达 Table 1 Expression of claudin-3 in colorectal carcinoma and adjacent normal tissues |

|
图 4 1例高分化结直肠癌病例癌旁正常组织(A)和自身癌组织(B)claudin-3表达的对比 Figure 4 Comparison of claudin-3 expression between adjacent normal tissue (A) and paired cancer tissue (B) in a case of well differentiated colorectal carcinoma (SP, ×200). |
Claudin-3蛋白在高分化组的强阳性表达率为21.43%,中分化组为36.84%,低分化组为85.71%,其中高分化组与中分化组间的claudin-3蛋白强阳性表达率的差异无统计学意义(P>0.05),而高分化组与低分化组间及低分化组与中分化组间的差异均有统计学意义(P < 0.05,P < 0.05,表 2)。结果提示,claudin-3蛋白的表达程度越强,肿瘤组织的分化程度越低。
| 表 2 Claudin-3在癌组的表达及强阳性表达率与临床病理参数之间的关系 Table 2 Expression of claudin-3 in the cancer tissues and the relationship between its strongly positive expression rate and the clinicopathological parameters of the patients |
淋巴结转移组claudin-3蛋白的强阳性表达率为61.11%,高于无淋巴结转移组的22.73%,差异有统计学意义(P < 0.05,表 2),表明claudin-3蛋白的表达强度与淋巴结转移相关。
2.2.3 远处转移在有远处转移的4例病例中,Claudin-3蛋白表达为强阳性和阳性者各2例,这4例的平均评分为4.50分。因病例数太少,无法得出有统计意义的结论,需更大样本的进一步研究。
2.2.4 其他参数不同年龄、性别、肿瘤部位、肿瘤最长径等各参数分组间claudin-3蛋白的强阳性表达率的差异均无统计学意义(P>0.05,表 2)。结果提示,claudin-3表达程度的强弱与这些因素无明显相关。
2.3 Claudin-3的表达强度与结直肠癌预后的关系14例死亡组病例中,6例claudin-3表达为强阳性,8例为阳性;19例存活组病例中,7例claudin-3表达强阳性,10例为阳性,2例为阴性。对这两组的claudin-3表达得分进行独立样本T检验,死亡组平均评分为4.50分,显著高于存活组的3.526分,差异有统计学意义(P=0.036,P < 0.05)。此结果说明claudin-3在癌组织中表达越强,预后可能越差。
3 讨论紧密连接是相邻细胞间重要的膜连接复合体[9],具有屏障功能、维持细胞极性及物质转运和信号传导等重要的生物学功能[10]。其中,claudin是决定紧密连接功能最重要的骨架蛋白[11]。claudin是一个多基因家族,目前已发现24种跨膜蛋白亚型,以claudin-l、-2、-3……-24命名[12]。claudin的表达异常直接影响紧密连接的完整性和功能的正常化[13],而紧密连接功能的改变是肿瘤转移过程中的一个关键影响因素[14]。大量研究证明,claudin在不同的肿瘤组织中表达各不相同,并发挥不同作用[15]。
近年来也有不少关于claudin-3与结直肠癌相关的研究报道[16-18]。这些研究均提示claudin-3的异常表达与结肠癌的发生、发展密切有关。本研究结果显示,在结直肠癌组织中的表达较癌旁正常组织显著升高(χ2=10.105,P=0.003,P < 0.05),claudin-3的异常表达可能与结肠癌的发生有关,表明claudin-3蛋白有可能成为结直肠癌早期诊断的检测指标。
目前,claudin-3的异常表达与肿瘤发生、发展之间关系的确切机制尚不完全清楚。Takehara等[19]以Caco2结肠癌细胞株为研究对象,发现claudin-3等的过表达能促进Caco2的侵袭力和细胞旁渗透能力,与肿瘤细胞的浸润、转移能力密切相关。Waldemir等[20]发现表皮生长因子(EGF)能增加结直肠癌细胞系HT-29细胞claudin-3表达,这种表达促进细胞迁移,同时增加了锚依赖和非锚依赖的新的癌巢的形成,说明过表达的claudin-3提高结直肠癌细胞的侵袭潜能;并且claudin-3的表达与表皮生长因子(EGF)相关,而EGF是多种恶性肿瘤发生时增高的标志物,EGF受体拮抗剂吉非替尼等已经应用于临床抗肿瘤治疗。Takala等[21]研究发现,claudin-3可能通过caspase-3途径影响细胞凋亡过程,导致肿瘤发生。还有研究认为,claudin蛋白能通过某种途径抑制免疫粘附分子,导致肿瘤细胞间黏附作用减弱、活动能力和活动范围增加,与肿瘤的发展及浸润转移密切相关[12]。其他相关研究也发现,claudin-3在许多上皮细胞肿瘤中表达上调,且其上调幅度与肿瘤组织学分级、淋巴结转移呈正相关[22]。为了进一步观察claudin-3的表达强度与肿瘤侵袭、转移的关系,我们对不同临床病理参数病例间的claudin-3表达强度进行了分析,结果显示,claudin-3的表达强度随着结直肠癌分化程度的不同差异明显,分化程度越低,肿瘤恶性程度越高,表达claudin-3蛋白的程度越强;并且在淋巴结转移组中claudin-3的表达强度显著高于无淋巴结转移组(P < 0.05),提示claudin-3蛋白表达增高可能参与了结直肠癌的浸润、转移过程,提示claudin-3有可能成为结直肠癌新的治疗靶点。
同样有研究认为,由于claudin-3主要表达在细胞膜上,可能可以作为一种潜在的药物治疗靶点。产气荚膜梭菌肠毒素是claudin-3和claudin-4蛋白的一种天然的配体,这种毒素与claudin-3、claudin-4蛋白结合可导致细胞迅速溶解[23]。最近有研究发现,CPE以表达claudin-3、-4蛋白的肿瘤细胞作为靶点,抑制这部分肿瘤细胞[24]。本研究发现,claudin-3在结直肠癌组织中高表达,提示CPE可能作为一种新的治疗结直肠癌的化合物,这为结直肠癌的治疗提供了一种新的思路,也是我们下一步深入研究的方向。
目前,claudin-3与癌症患者生存时间的研究报道甚少。Che等[25]对claudin-3表达水平与鳞状上皮细胞癌的预后以及潜在机制进行了研究,结果显示,claudin-3蛋白水平的降低与肿瘤TNM分期、淋巴结转移及肿瘤复发显著相关,claudin-3蛋白水平是影响总体存活率的独立预后因素,可作为鳞状上皮细胞癌潜在的预后因素。Jiang等[26]研究发现,claudin-3是肝癌的一个潜在预后标志物,它与肝癌患者的生存期显著相关(P=0.021),并且claudin-3是总体生存率的独立预后因素(P=0.014)。本研究中,我们对claudin-3的表达强度与结直肠癌预后的关系进行了观察分析,结果显示,死亡组claudin-3表达平均评分为4.50分,显著高于存活组病例的3.526分,差异有统计学意义(P < 0.05),表明claudin-3在癌组织中表达越强,预后可能越差,提示claudin-3可能成为判断结直肠癌预后的标志物。
由于本研究样本量有限及缺少相关机制研究,claudin-3能否成为结直肠癌早期诊断或判断预后的标志物,以及claudin-3蛋白表达异常与结直肠癌的相互机制是我们下一步研究重点。同时,claudin-3蛋白能否作为结直肠癌的治疗靶点也有待我们深入基础和临床研究。
| [1] | Chen W, Zheng R, Baade PD, et al. Cancer statistics in China, 2015[J]. CA Cancer J Clin, 2016, 66 (2): 115-32. DOI: 10.3322/caac.21338. |
| [2] | Sánchez-Tilló E, de Barrios O, Siles L, et al. β-catenin/TCF4 complex induces the epithelial-to-mesenchymal transition (EMT)-activator ZEB1 to regulate tumor invasiveness[J]. Proc Natl Acad Sci USA, 2011, 108 (48): 19204-9. DOI: 10.1073/pnas.1108977108. |
| [3] | Wang H, Yang X. The expression patterns of tight junction protein claudin-1, -3, and -4 in human gastric neoplasms and adjacent non-neoplastic tissues[J]. Int J Clin Exp Pathol, 2015, 8 (1): 881-7. |
| [4] | Karabulut M, Alis H, Bas K, et al. Clinical significance of serum claudin-1 and claudin-7 levels in patients with colorectal cancer[J]. Mol Clin Oncol, 2015, 3 (6): 1255-67. |
| [5] | de Oliveira S, de Oliveira M, De Souza W, et al. Claudins upregulation in human colorectal cancer[J]. FEBS Lett, 2005, 579 (27): 6179-85. DOI: 10.1016/j.febslet.2005.09.091. |
| [6] | 马兰芳. claudiN-3.claudin-4在结直肠腺瘤和结直肠癌中的表达[D].石家庄:河北医科大学, 2015. http://cdmd.cnki.com.cn/Article/CDMD-10089-1015324362.htm |
| [7] | Oliveira SS, Morgado-Díaz JA. Claudins: multifunctional players in epithelial tight junctions and their role in cancer[J]. Cell Mol Life Sci, 2007, 64 (1): 17-28. DOI: 10.1007/s00018-006-6314-1. |
| [8] | Soini Y. Expression of claudins 1, 2, 3, 4, 5 and 7 in various types of tumours[J]. Histopathology, 2005, 46 (5): 551-60. DOI: 10.1111/his.2005.46.issue-5. |
| [9] | Hossain Z, Hirata T. Molecular mechanism of intestinal permeability: interaction at tight junctions[J]. Mol Biosyst, 2008, 4 (12): 1181-5. DOI: 10.1039/b800402a. |
| [10] | Lee B, Huang E, Ward J. Tight junction biology and kidney dysfunction[J]. Am J Physiol Renal Physiol, 2006, 290 (1): F20-34. |
| [11] | Khan N, Asif R. Transcriptional regulators of claudins in epithelial tight junctions[J]. Mediators Inflamm, 2015 : 219843. |
| [12] | 王琳, 李世拥. CLDN在结直肠癌组织中的表达及研究进展[J]. 肿瘤学杂志, 2012, 18 (6): 470-4. |
| [13] | Morin PJ. Claudin proteins in human cancer: promising new targets for diagnosis and therapy[J]. Cancer Res, 2005, 65 (21): 9603-6. DOI: 10.1158/0008-5472.CAN-05-2782. |
| [14] | Webb PG, Spillman MA, Baumgartner HK. Claudins play a role in normal and tumor cell motility[J]. BMC Cell Biol, 2013, 14 : 19. DOI: 10.1186/1471-2121-14-19. |
| [15] | 邵瑞颖, 石莎, 李森林. 紧密连接蛋白Claudins与胃癌关系的研究进展[J]. 胃肠病学和肝病学杂志, 2015, 24 (10): 1171-4. |
| [16] | Soler AP, Miller RD, Laughlin KV, et al. Increased tight junctional permeability is associated with the development of colon cancer[J]. Carcinogenesis, 1999, 20 (8): 1425-31. DOI: 10.1093/carcin/20.8.1425. |
| [17] | Mees ST, Mennigen R, Spieker T, et al. Expression of tight and adherens junction proteins in ulcerative colitis associated colorectal carcinoma: upregulation of claudin-1, claudin-3, claudin-4, and beta-catenin[J]. Int J Colorectal Dis, 2009, 24 (4): 361-8. DOI: 10.1007/s00384-009-0653-y. |
| [18] | Nübel T, Preobraschenski J, Tuncay H, et al. Claudin-7 regulates EpCAM-mediated functions in tumor progression[J]. Mol Cancer Res, 2009, 7 (3): 285-99. DOI: 10.1158/1541-7786.MCR-08-0200. |
| [19] | Takehara M, Nishimura T, Mima S, et al. Effect of claudin expression on paracellular permeability, migration and invasion of colonic cancer cells[J]. Biol Pharm Bull, 2009, 32 (5): 825-31. DOI: 10.1248/bpb.32.825. |
| [20] | de Souza WF, Fortunato-Miranda N, Robbs BK, et al. Claudin-3 overexpression increases the malignant potential of colorectal cancer cells: roles of ERK1/2 and PI3K-Akt as modulators of EGFR signaling[J]. PLoS One, 2013, 8 (9): e74994. DOI: 10.1371/journal.pone.0074994. |
| [21] | Takala H, Saarnio J, Wiik H, et al. Claudins 1, 3, 4, 5 and 7 in esophageal cancer: loss of claudin 3 and 4 expression is associated with metastatic behavior[J]. APMIS, 2007, 115 (7): 838-47. DOI: 10.1111/apm.2007.115.issue-7. |
| [22] | 姚永强, 韩雪, 曹铭谦, 等. 紧密连接蛋白Claudin-3在人乳腺癌组织的表达与临床意义[J]. 现代中西医结合杂志, 2014 (30): 3329-31. |
| [23] | Long H, Crean CD, Lee WH, et al. Expression of clostridium perfringens enterotoxin receptors claudin-3 and claudin-4 in prostate cancer epithelium[J]. Cancer Res, 2001, 61 (21): 7878-81. |
| [24] | English DP, Santin AD. Claudins overexpression in ovarian cancer: potential targets for Clostridium Perfringens Enterotoxin (CPE) based diagnosis and therapy[J]. Int J Mol Sci, 2013, 14 (5): 10412-37. DOI: 10.3390/ijms140510412. |
| [25] | Che J, Yang Y, Xiao J, et al. Decreased expression of claudin-3 is associated with a poor prognosis and EMT in completely resected squamous cell lung carcinoma[J]. Tumour Biol, 2015, 36 (8): 6559-68. DOI: 10.1007/s13277-015-3350-1. |
| [26] | Jiang L, Yang D, Fu L, et al. CLDN3 inhibits cancer aggressiveness via Wnt-EMT signaling and is a potential prognostic biomarker for hepatocellular carcinoma[J]. Oncotarget, 2014, 5 (17): 7663-76. DOI: 10.18632/oncotarget. |
 2017, Vol. 37
2017, Vol. 37

